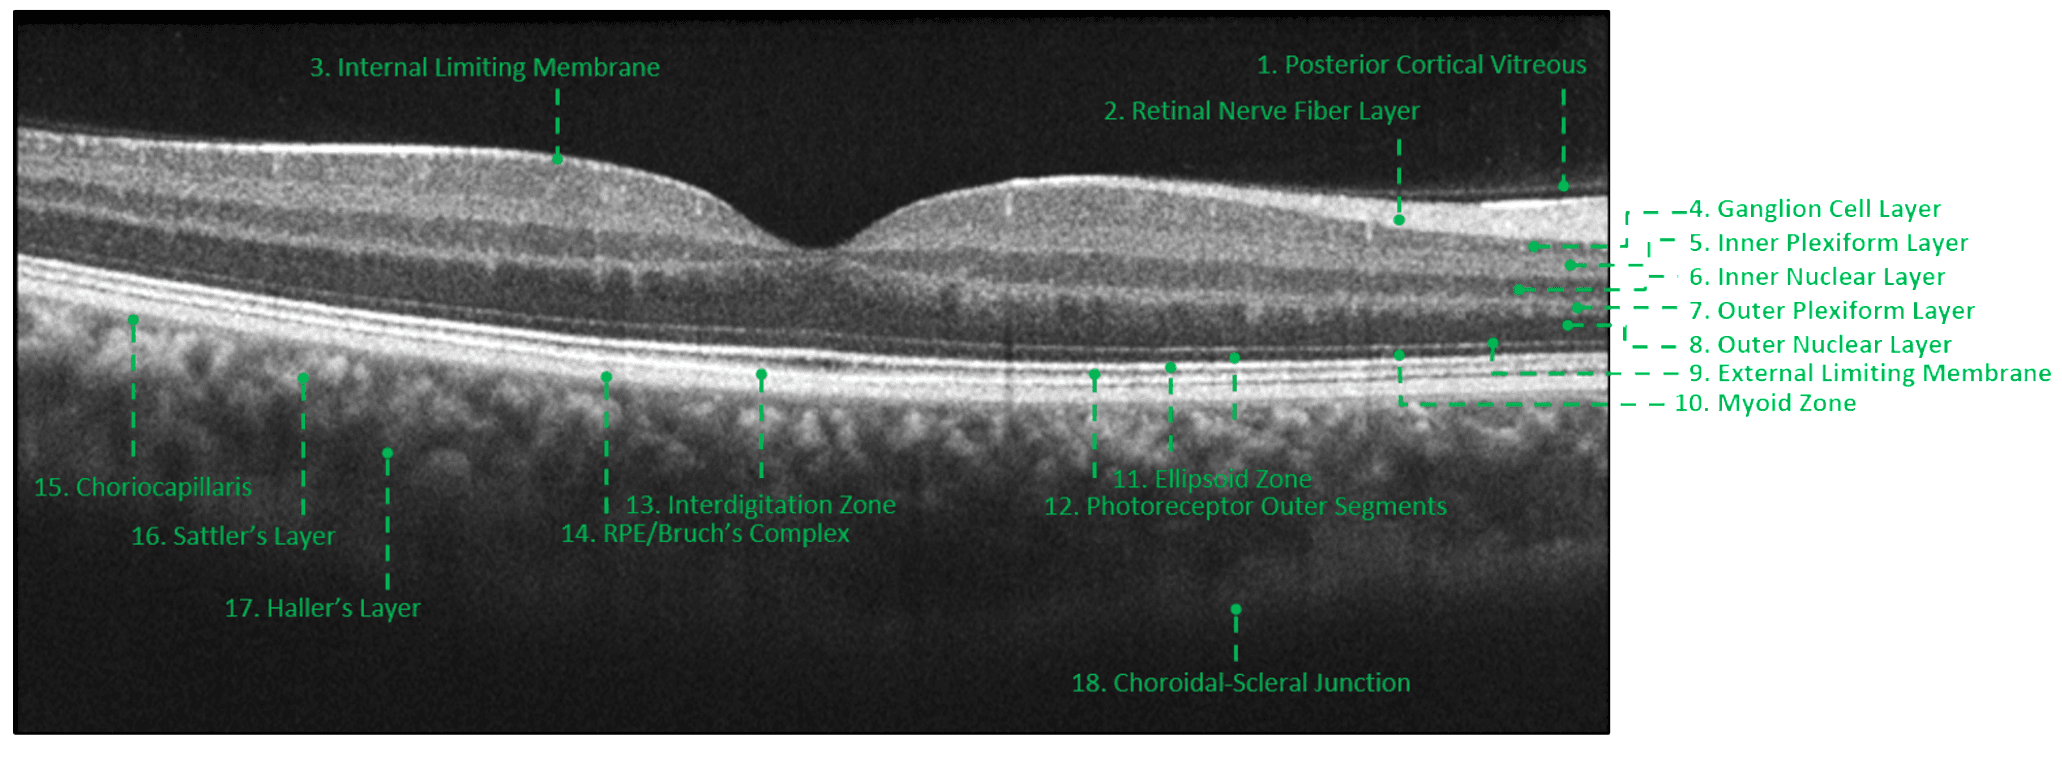
From MIT Bootcamp to Glucotek

AirPods Max 2 Arrive: Apple Refines Premium Headphones with H2 Chip
Apple’s second-generation AirPods Max are now available for purchase, bringing improvements to active noise cancellation (ANC), sound quality, and feature set, powered by the H2 chip. The new headphones maintain the same overall design as their predecessors, but introduce key upgrades focused on audio performance and intelligent features.

The core enhancement lies within the H2 chip, enabling up to 1.5x more effective ANC compared to the previous generation. This improved noise cancellation aims to provide a more immersive listening experience by reducing distractions from sources like airplane engines or commuter trains. Transparency mode, as well benefiting from the H2 chip, is designed to sound more natural, allowing users to remain aware of their surroundings.
Beyond noise control, the H2 chip unlocks new features including Adaptive Audio, Conversation Awareness, Voice Isolation, and Live Translation. Adaptive Audio dynamically adjusts ANC and Transparency levels based on the user’s environment. Conversation Awareness lowers content volume and reduces background noise when a user begins speaking to someone nearby. Voice Isolation prioritizes the user’s voice during calls although minimizing ambient noise, and Live Translation facilitates real-time communication across languages.
The AirPods Max 2 also offer enhancements for content creators, with studio-quality audio recording capabilities and a camera remote function. Sound quality has been improved with a new high dynamic range amplifier, and Apple reports reduced wireless audio latency.
The headphones are available in five colors – midnight, starlight, orange, purple, and blue – and retain the USB-C port for charging and lossless audio. Battery life remains at 20 hours with ANC enabled.
Context Box: The H2 Chip
The H2 chip is a system on a chip (SoC) designed by Apple, and represents a significant upgrade in processing power and efficiency compared to the original AirPods Max’s H1 chip. It enables the advanced computational audio features found in the AirPods Max 2, including improved ANC, Transparency mode, and the new Adaptive Audio and Live Translation capabilities. The H2 is also featured in the second-generation AirPods Pro.
While the design remains unchanged, a common point of criticism for the original AirPods Max – their weight and size – has not been addressed in this iteration. Early reviews indicate the core experience is improved, but the fundamental form factor remains the same.
Are these refinements enough to solidify the AirPods Max 2’s position as the premium over-ear headphone choice, or will the unchanged design continue to be a barrier for some potential buyers?